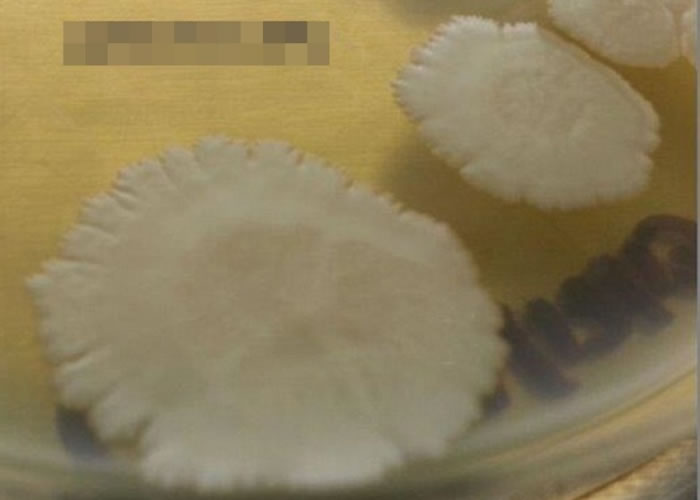
ϸ̫յٶȸ졣

研究显示部分细菌不但能够适应太空环境 而且比在地球生长得更好
部分细菌在太空的生长速度更快。
(蜘蛛网报道)细菌更适合在太空生存?外国一个团队为研究地球的细菌如何影响太空人的健康,于约两年前把部分地球细菌的样本送到国际太空站研究,结果显示部分细菌不但能够渐渐适应太空的环境,而且比在地球时可以生长得更好,惟暂未得知箇中原因。
研究员于2014年,在美国佛罗里达州采集了48种非致病性细菌作样本,再送到国际太空站作研究,并定期观察细菌的变化,每次观察期为4天,而每个观察期会相隔24小时。研究员于2015年2月把样本送回加州大学作检验,发现大部分细菌的生长情况与在地球时没太大分别,其中3个样本在太空的生长速度,更比在地球时快近60%。
专家暂时未清楚箇中原因,但估计或是因为太空无重力的环境有关。研究员科伊尔(David Coil)表示:“我估计是因为太空的重力较少,而此环境更有利细菌的生长...惟仍要多深入的实验才可证实。”